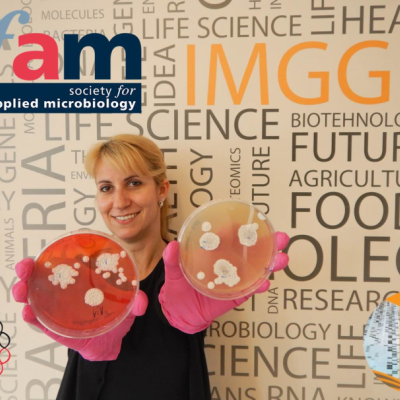

News





Bojana Banovic Djeri, PhD, awarded Innovation Fund's Proof of Concept grant
23 February 2021

Nemanja Stanisavljevic, PhD, awarded Innovation Fund's Proof of Concept grant
04 February 2021


There is no more content to load